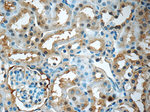
GNPDA2 Antibody in Immunohistochemistry (Paraffin) (IHC (P))

Search
Proteintech
GNPDA2 Polyclonal Antibody
{{$productOrderCtrl.translations['antibody.pdp.commerceCard.promotion.promotions']}}
{{$productOrderCtrl.translations['antibody.pdp.commerceCard.promotion.viewpromo']}}
{{$productOrderCtrl.translations['antibody.pdp.commerceCard.promotion.promocode']}}: {{promo.promoCode}} {{promo.promoTitle}} {{promo.promoDescription}}. {{$productOrderCtrl.translations['antibody.pdp.commerceCard.promotion.learnmore']}}

Please note: We are reviewing Western blot images included in the antibody testing data in our catalog, including those provided by third parties. Unless expressly labeled or annotated as “raw-unedited”, Western blot images included in the antibody testing data in our catalog may have been edited, optimized or otherwise adjusted for presentation.
Product Details
17105-1-AP
Species Reactivity
Published species
Host/Isotype
Class
Type
Immunogen
Conjugate
Form
Concentration
Amount
Purification
Storage buffer
Contains
Storage conditions
Shipping conditions
Product Specific Information
Immunogen sequence: MRLVILDNY DLASEWAAKY ICNRIIQFKP GQDRYFTLGL PTGSTPLGCY KKLIEYHKNG HLSFKYVKTF NMDEYVGLPR NHPESYHSYM WNNFFKHIDI DPNNAHILDG NAADLQAECD AFENKIKEAG GIDLFVGGIG PDGHIAFNEP GSSLVSRTRL KTLAMDTILA NAKYFDGDLS KVSTMALTVG VGTVMDAREV MILITGAHKA FALYKAIEGV NHMWTVSAFQ QHPRTIFVCD EDATLELRVK TVKYFKGLMH VHNKLVDPLF SMKDGN (1-275 aa encoded by B C015532)
Target Information
GNPDA2 (Glucosamine-6-phosphate deaminase) is an allosteric enzyme that catalyzes the reversible conversion of D-glucosamine-6-phosphate into D-fructose-6-phosphate and ammonium. GNPDA2 is the second mammalian glucosamine-6-phosphate deaminase discovered, and is closer in structure and activity to the E. coli enzyme than GNPDA1. GNPDA1 possesses greater affinity for ammonium than either GNPDA2 or the E. coli enzyme suggesting that the forward reaction of D-glucosamine-6-phosphate into D-fructose-6-phosphate and ammonium is catalyzed at a slower rate than GNPDA2.
For Research Use Only. Not for use in diagnostic procedures. Not for resale without express authorization.
Bioinformatics
Protein Aliases: GlcN6P deaminase 2; Glucosamine-6-phosphate deaminase 2; Glucosamine-6-phosphate isomerase 2; Glucosamine-6-phosphate isomerase SB52; GNPDA 2; oscillin
Gene Aliases: 4921523I18Rik; 4933412A11Rik; BB189630; GNP2; GNPDA; GNPDA2; Kiaa4008; mKIAA4008; Sb52
UniProt ID: (Mouse) Q9CRC9
Entrez Gene ID: (Mouse) 67980, (Rat) 289608

Performance Guarantee
If an Invitrogen™ antibody doesn't perform as described on our website or datasheet,we'll replace the product at no cost to you, or provide you with a credit for a future purchase.*
Learn more
We're here to help
Get expert recommendations for common problems or connect directly with an on staff expert for technical assistance related to applications, equipment and general product use.
Contact tech support

